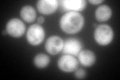
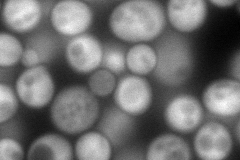
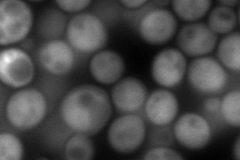
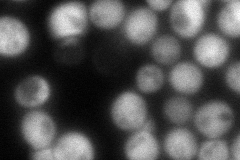
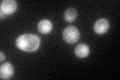

View description
Deoxyhypusine hydroxylase, a HEAT-repeat containing metalloenzyme that catalyzes hypusine formation; binds to and is required for the modification of Hyp2p (eIF5A); complements S. pombe mmd1 mutants defective in mitochondrial positioning
Localization:
Intensity:
Fold change:
Significance:
-
C’ GFP library in SD
cytosol225.81 -
N' NOP1pr-GFP in SD
cytosol215.21 -
N' TEF2pr-mCherry in SD
cytosol346.502 -
N' NATIVEpr-GFP in SD
nucleus82.2975 -
N' TEF2pr-VC and Cyto-VN in SD

cytosol79.7894 -
C’ GFP library in SD+DTT

cytosol136.740.6No -
C’ GFP library in SD+H2O2

cytosol177.80.78No -
C’ GFP library in Starvation Media
nucleusN/AN/AYes -
C’ GFP library on the background of Pup2-DaMP

cytosol -
C’ GFP library on the background of CCT mutant

cytosol245.5391.08731No
